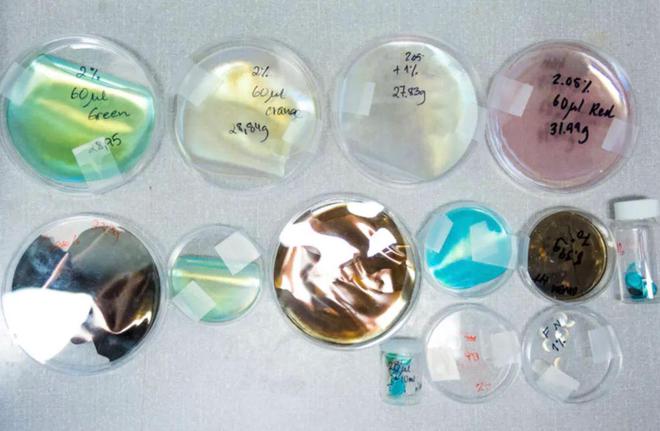

米乐中国 m6平台官网备受爱美人士追捧,但这些效果往往依赖于含有毒性的颜料、塑料基材料或金属箔来实现。
这些亮片或闪粉的核心材料,通常是石油基材料为主的PVC、聚酯或PET。它们非常小,是平均不到五毫米的微塑料,而且不可生物降解。当它们泄漏到我们的江河湖海中,鱼虾等生物会被看起来像食物的小闪亮颗粒吸引,并吃掉它们,这些合成塑料最终会进入我们的食物链。
这些小颗粒不仅加剧了全球微塑料污染问题,而且含有的生物累积性化学物质,如致癌物和激素干扰物,对经常处理它们的工人健康构成了严重威胁 。

好在人类一直擅长向大自然学习。在自然界的广阔舞台上,色彩的魔法无处不在。
自然界的色彩多样性主要分为两大类:化学色和结构色。化学色依靠特定色素分子对光的吸收和反射,为生物体提供了丰富多彩的色彩表现,但会因为色素的流失或改变而褪色、变色,缺乏色彩持久性。
结构色与传统颜料或染料不同,它来自生物表面结构对光的反馈。通过光与物质微观结构相互作用,在微纳尺度上产生独特的光学效应,不仅更加鲜艳动人,而且更为恒久,洁净环保。
自然界最鲜艳的颜色——孔雀羽毛、蝴蝶翅膀——就是通过微观上的纳米结构创造的。它们的颜色常常色感鲜亮、明艳,并会随着光线的入射角度和观察者的位置而发生改变,显得难以预测和复制。只要保持其周期性的结构,结构色就能保持其不褪色的特性,展现出持久的美丽。

在这个对环保和可持续性日益重视的时代,生物基材料响应了对环保时尚日益增长的需求。在众多的仿生结构色候选材料中,纤维素纳米晶体(CNC)由于其来源广泛、物理化学性质优异、与生物体具有良好的相容性而受到了广泛关注。

多糖,以其可再生性、生物可降解性和优异的生物相容性,正逐渐成为功能性纳米材料领域备受瞩目的原料。纤维素即是一种多糖类高结晶度天然高分子,其生物质来源广泛,包括木材、棉花、苎麻、农作物秸秆、竹子、海藻等天然植物,菠萝、柠檬等果实表皮,细菌等微生物以及海鞘等被囊类动物。
生物质资源中的纤维素在微生物合成或分泌的多糖降解酶作用下可高效降解,符合取自大自然、回归自然,经加工设计能构建可持续环境友好材料的发展理念。

通过物理切割剥离、酶水解、化学酸解或氧化处理的自上而下(top-down)方法可去除生物质资源中的无定形纤维素和半结晶纤维素,得到刚性短棒状的纤维素纳米晶(Cellulose Nanocrystal, CNC)。
纳米晶体指晶粒为纳米尺寸的晶体材料,或具有晶体结构的纳米颗粒。该结晶结构的有序性周期性规则结构则能与光线产生各种奇妙的相互作用。
研究人员发现,CNC水性胶体悬浮液可在纳米尺度上自发自组织,经过处理,能够简单有效地形成周期性规则的螺旋排列结构,从而形成五彩缤纷的彩色薄膜。


目前制备CNC手性向列型固态薄膜常采用两种制备策略:蒸发诱导自组装(EISA)和真空辅助自组装(VASA)。其中EISA最为常用,即将CNC悬浮液置于容器中,在恒定温度和湿度的条件下使溶剂不断蒸发,完全干燥后,这种有序性可以保留到固态,从而实现对可见光的特定反射,以得到具有结构色的CNC薄膜。利用这种自组装方法,可以产生整个可见光谱中的各种颜色,并将其与引人注目的视觉效果相结合,如彩虹色或金属光泽。

纤维素的来源十分广泛,从树木、果皮、藻类到旧牛仔布或废纸。 现如今, CNC 材料的多种机制和应用已在时尚和装饰领域创造出令人惊叹的视觉盛宴。这些材料能够实现流光溢彩的涂层、绚丽的亮片和闪光粉等效果,为设计师们提供了无限的创意可能。作为可再生、可生物降解的环保材料, CNC 在实现这些视觉体验的同时,更助力于打造可持续发展的未来。

毕业于伦敦中央圣马丁学院生物设计硕士专业的Célina Camboni,不但是奢侈品和时尚管理的专业人士,也是在生物时装设计领域独树一帜的创新者。
她所倡导的生物彩虹涂层技术,是对自然界光学现象的一次巧妙模仿,该涂层采用了尖端的纳米制造技术,旨在创造一种全新的生态友好型色彩解决方案。Célina以CNC为基础创造出革命性材料,进一步拓展了生物虹彩薄膜的应用范围,将其应用于废旧的再生织物和材料,为时尚界提供了一种环保的替代途径。
Célina的A Living Colour项目就是一个基于生物彩虹涂层开创性的生物服装研究,并获得了LVMH集团的财政支持。

Célina在项目中精心打造了一件蓬松外套,其设计灵感融合了蝴蝶翅膀上的微小鳞片结构和传统高级定制皮草大衣的元素。外套独特的形状和色彩变化仿效了蝴蝶鳞片的排列。这件外套采用了旧时装废料,通过巧妙的手工缝制,并涂上一层生物彩虹膜,展现了独特的美感。
通过这些实验,Célina证明了她的生物虹彩涂层工艺不仅具有艺术美感,而且能够与多种纺织品兼容,这为时尚界提供了一种新的视角和可能性。Célina也尝试在其他面料上应用生物彩虹涂层。


在丝绸上,涂层呈现出独特的彩光效果,从亮蓝到金属绿,色彩的变幻无穷,为每件作品增添了独特的魅力。
Célina还尝试将生物彩虹涂层用于损坏的旧皮革和皮革残渣,创造可持续的色 彩效果。
和Célina Camboni的研究类似,来自阿尔托大学的博士研究生Konrad Klockars和博士研究生Noora Emilia Yau合作成立了结构色彩工作室(SCS),以期将装饰性材料取材于木,返用于木。
该工作室是一个综m6米乐平台 米乐官方网站合平台,使用艺术、科学、技术和设计等方法开发可持续的结构色彩,并将其应用于家具和建筑元素。Konrad Klockars作为材料研究员,Noora Yau作为设计师,共同利用纳米纤维素制作了众多结构色作品。

传统上,木材的色彩给人以质朴、沉稳的印象,常与棕色、灰色和绿色等自然色调相联系。SCS的技术颠覆了这一刻板印象,将木材转化为具有闪亮光泽和彩虹般绚丽色彩的材质。木材这一古老材料得以焕发新生,展现出前所未有的现代感和艺术魅力。


无需依赖任何颜料或染料,木材本身就能通过自然的方式展现出生动而鲜明的色彩。日本传统的炙烤技术赋予了木材深邃的黑色,同时保留了其天然的纹理和质感。在这种深色背景上,涂层的光学效应得到了最大化的发挥,使得色彩在深色表面上呈现出更加明亮、更加浓郁的视觉效果。


Yau 和 Klockars 的着色实验还 扩展到涂层金属、塑料、木材和m6米乐平台 米乐官方网站织物。
除了作为着色涂层成为设计材料的一部分, CNC 本身也可被直接制作成材料,应用于时尚行业。
Radiant Matter的创始人兼CEO Elissa Brunato,在中央圣马丁艺术与设计学院攻读材料未来硕士学位期间,得到了瑞典研究院科学家Hjalmar Granberg和Tiffany Abitbol的支持,成功研发了生物彩虹亮片这一创新材料。
在与亮片供应商的交流中,她意识到时尚品如Stella McCartney 和 LVMH 集团对更具可持续性的材料的需求日益增长,这促使她开发了这种新材料。
Elissa以其对自然的深刻理解和创新精神,利用生物技术的潜力,以木材为原料,创造了这种色泽动人且由天然纤维素制成的闪光亮片。


Elissa的方法始于对生产系统和亮片最终去向的深刻理解。这指引着她重新设计材料的整个生命周期旅程。亮片在工业层面上无法回收,这让她意识到,设计出一种能够融入生物系统的产品至关重要。她的目光投向了大自然,观察那些自然中闪闪发光的物体 —— 蝴蝶的翅膀、甲虫的外壳,或是鱼类的鳞片。她思考着,为何不模仿大自然正在做的事情呢?因此,她特别选择了纤维素作为材料,因为它是一种快速更新的资源。
在Elissa 看来,重复历史,使用金属或矿物是没有意义的。这些材料会使产品变得沉重,而且它们是更新速度较慢的宝贵资源。她追求的是一种可以大量使用,即便泄漏也不会对环境造成危害的材料,这是设计的核心。

“ 这就是为什么我认为纤维素是这个故事中最重要的部分。” Elissa 在接受采访时说道。她的目标是创造出既美观又可持续的产品,这正是她通过使用纤维素,这种快速更新且对环境友好的资源所实现的。
Elissa 采用了一种独特的工艺流程,使得生产亮片的过程几乎不产生废物。通常,亮片是从大片材料中通过冲压切割出来的,这种方法大约会产生 30% 的材料浪费。然而,她所制作的亮片却避免了这种情况,没有产生任何材料的边角料。
她所创造的亮片,利用 CNC 的微观晶体结构折射光线,自然呈现出闪光效果,无需依赖颜料、染料、金属或矿物质。由于材料之间形成了非常强的键,因此只需要使用极少量的纤维素,获得的亮片也极为轻巧。
未来,人们使用这样装饰性亮片的应用范围会更广。Brunato指出:“如果我们考虑到一棵树生长并形成足够的纤维素来制造亮片所需的时间,大约需要一百年,这与形成原油所需的成千上万年相比,确实显得非常短暂。”

Elissa的作品得到了 LVMH 集团的认可,并获得了 Green Trail 奖。她成为 2022 年艺术基金会材料创新研究员,并赢得了 Mills 面料材料创新奖、Mills Fabrica 创新实验室驻留计划、MullenLowe NOVA 创意创新奖,并入围纽约 Dorothy Waxman 国际纺织品设计奖决赛。她的作品入选了维特拉设计博物馆的创新展“塑料:重塑我们的世界”,并成为伦敦设计博物馆“材料故事”的一部分,这是一个为期 5 年的巡回展览,展出了定义现代生活的材料。
Elissa Brunato 的创新不仅为时尚界带来了一种新的选择,更为我们对自然界的理解和尊重提供了新的视角。

除了亮片,时尚界也常以细腻的闪光粉作为装饰元素,它们如同点点星光,为设计带来缤纷夺目的视觉效果。然而,传统闪光粉和颜料往往含有有毒化合物或微塑料,对环境和健康构成潜在威胁,但源自植物中的纤维素的闪光粉正在改变这一局面。
来自英国剑桥大学的化学家Silvia Vignolini的团队在《自然材料》杂志上于11月11日发表了关于这种闪光粉的研究成果。他们的创意灵感汲取自非洲植物Pollia condensata,这种植物以其鲜艳的蓝色果实而闻名,被称为大理石浆果。在这些浆果中,纤维素纤维以一种特殊的方式反射光线,形成了独特的金属蓝色调。“如果植物能做到这一点,我们也应该能够做到。”Silvia如是说。

这种基于植物的闪光粉为手工艺品的环保转型提供了新途径。它同样适用于油漆、化妆品或包装材料中,以作为一种闪亮的颜料成分。
Silvia的团队将纤维素纤维与水混合,形成一种特殊的水基混合物。这些纤维在水中仿佛细小的棒子,当团队将这种液体倾倒在塑料板上并让其干燥时,纤维素纤维会自然沉淀,形成类似螺旋楼梯的结构。通过调整这些结构的倾斜度,团队能够改变它们反射光线的波长,从而改变薄膜的颜色,就像童话中将稻草纺成金子的魔法一样,他们将普通的植物浆液转变成了光彩夺目的丝带,这些丝带展现出彩虹般的绚丽色彩。

当这些丝带从平台上剥离后,可以进一步加工成闪光粉。“我们可以使用任何类型的纤维素,”Vignolini解释说。她的团队选择了来自木浆的纤维素,但纤维素同样存在于果皮中,也可以从纺织业剩余的棉纤维中提取。虽然研究人员还需要进一步测试这种新型闪光粉对环境的影响,但Vignolini对这种天然材料的潜力和未来充满了乐观和信心。
重新设想地球上现有材料的前景,可以让我们以更安全、更环保的方式,打造出熠熠生辉的色彩。这些方法有可能以更具前瞻性和创新性的方式超越曾经的选择。